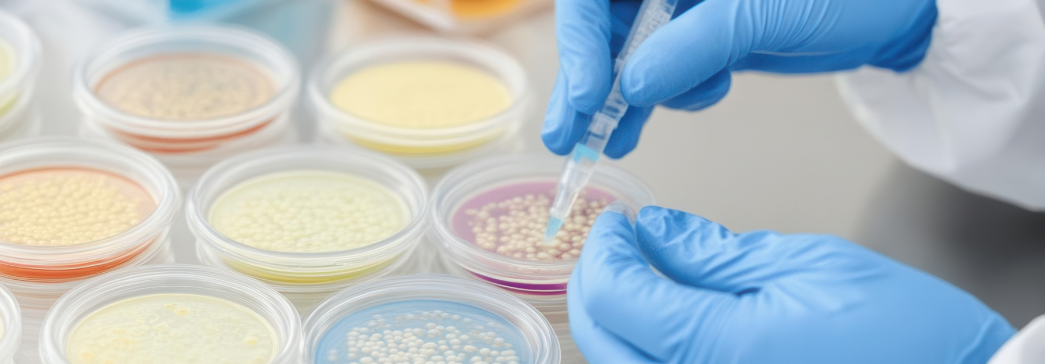
Arte e Cultura

Vitrine tecnológica
Laboratório de Microbiologia Experimental
Saúde e Bem-estar
Descrição do grupo de pesquisa:
O grupo de pesquisa em Microbiologia Experimental tem por objetivo estudar os mecanismos de patogenicidade das doenças infecciosas e parasitárias. Nosso grupo trabalha como modelo animal de doenças infecciosas com ratos Wistar neonatos, jovens e adultos. O grupo de pesquisa investiga a resposta imune do hospedeiro, patogênese do microrganismo, dano cognitivo em novas possibilidades terapêuticas.
Líderes:
Maria Inês da Rosa
Linhas de pesquisa:
Diagnostico Clinico e laboratorial das meningites
Doenças periodontais
Mecanismos de patogenicidade das doenças infecciosas
Patogênese e fisiopatologia da meningite bacteriana
CNPQ:
http://dgp.cnpq.br/dgp/espelhogrupo/17358
Contato:
Entre em contato com os responsáveis;
E-mail: tba@unesc.net
Telefone: (48) 3431-2577


